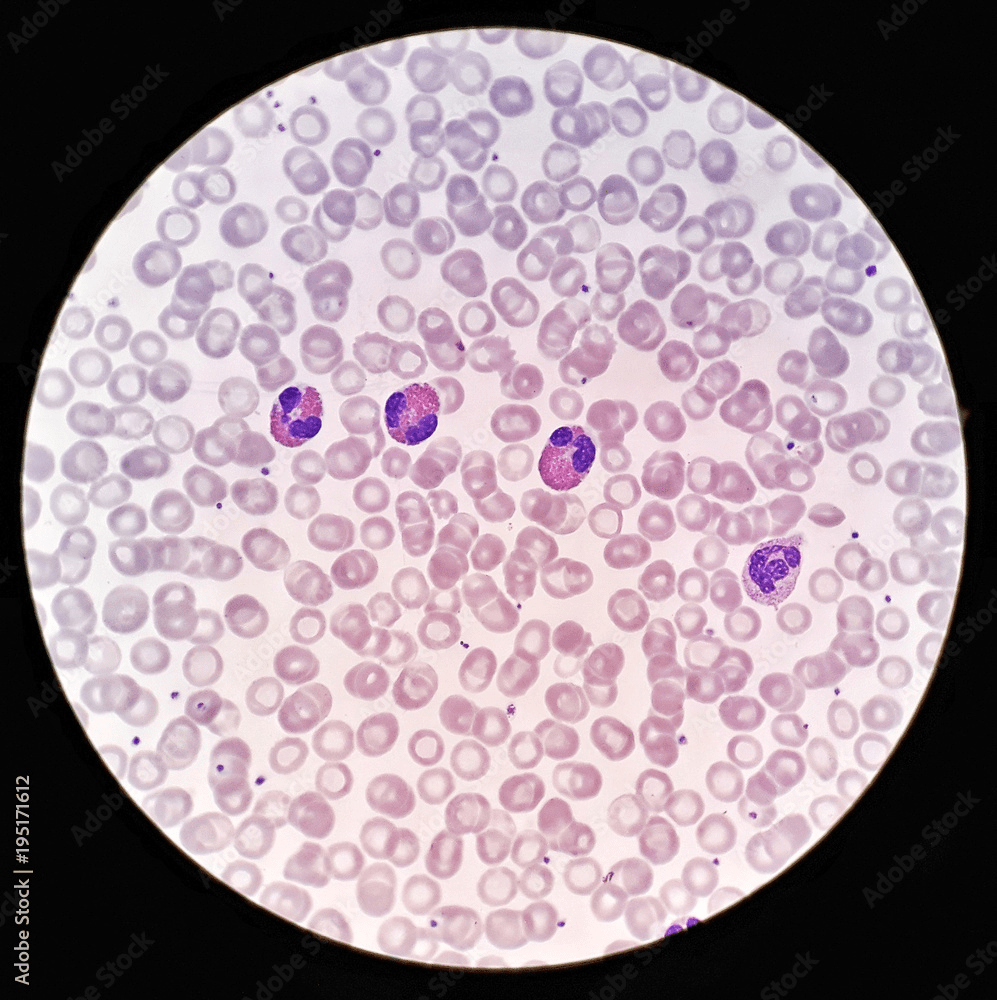

Ճանաչողական այց ԵՊՀ կենսաբանության ֆակուլտետ
Գիտելիքի օրը կրթահամալիրում ստանդարտ դասապրոցեսով չի կազմակերպվում , իրականացվում են բազմաթիվ ճամփորդությունները և հետաքրքիր հանդիպումներ, ես ընտրել էի ճամփորդություն ԵՊՀ կենսաբանության ֆակուլտետ։
Այցի ընթացքում մեր խումբը ծանոթացավ տարբեր լաբորատորիաներում իրականացվող հետաքրքիր ու կարևոր աշխատանքներին։
Սկզբում այցելեցինք մանրէաբանության լաբորատորիա, որտեղ մասնագետները փորձում էին թափոններից ստանալ այլընտրանքային էներգիա։ Այստեղ մենք նաև տեսանք նորագույն սարքավորումներ, ինչպես նաև դիտարկեցինք խմորասնկեր ու բակտերիաներ։
Այնուհետև այցելեցինք կենսաքիմիական լաբորատորիա։ Այստեղ իրականացվում էին հետազոտություններ, որոնք ուղղված էին քաղցկեղի բուժման դեղորայքի հայտնաբերմանը։ Մասնագետները սպիտակ առնետների մոտ առաջացնում էին կրծքագեղձի քաղցկեղ և փորձում բուժել այն տարբեր մեթոդներով՝ ուսումնասիրելով դեղամիջոցների արդյունավետությունը։
Մեկ այլ լաբորատորիայում մենք տեսանք կարիճների բուծում։ Պարզվեց, որ նրանց թույնը նույնպես օգտագործվում է բժշկության մեջ՝ որպես արժեքավոր դեղամիջոց։
Շատ հետաքրքիր տեղեկություններ ստացանք նաև մարդու աղիներում բնակվող մանրէների մասին։ Մենք հասկացանք, թե որքան մեծ է դրանց դերը մարդու առողջության պահպանման գործում։
Այցը շատ ուսուցողական և ոգևորող էր։ Այն մեզ օգնեց համոզվել, որ կենսաբանությունը մեր ժամանակի ամենազարգացող և պահանջված գիտություններից մեկն է։ Կարելի է վստահ ասել, որ այն դարի մասնագիտություն է։
Այս ամառ մեր ճամբարում արեցինք տարբեր հետաքրքիր նախագծեր։ Մանրադիտակով ուսումնասիրեցինք բույսերի հյուսվածքներ, հերձանցքներ ու արյան ձևավոր տարրերը, ինչը օգնում էր ավելի լավ պատկերացնել տեսածն ու կապել այն կենսաբանության մեջ սովորածի հետ։ Ուսումնասիրեցի նաև սնկեր, որոնք վարակում են միջատներին ու կարողանում են վերահսկել նրանց վարքագիծը։
Թարգմանել ենք տեսանյութ և գրական ստեղծագործություն, ինչը ոչ միայն հետաքրքիր փորձ էր, այլ նաև օգնում էր զարգացնել անգլերենի իմացությունը և մտածել, թե ինչպես ճիշտ փոխանցել գաղափարը։
Բացի նախագծերից, այցելել ենք նաև Գեղարոտի ջրվեժը։ Այս ճամփորդության ընթացքում ես ունեցա նոր հիշողություններ, սովորեցի նոր բաներ ու լավ ժամանակ անցկացրեցի։
Այս ճամբարը իմ վերջինն էր, և ես բավականին գոհ եմ մեր կատարած աշխատանքով։ Աշխատանքները հետաքրքիր էին, տարբերվող, և ամեն մեկը ինչ-որ նոր բան տվեց ինձ՝ թե՛ գիտելիքով, թե՛ փորձով։ Այս ամենը ոչ միայն ուսուցողական էր, այլ նաև հաճելի և հիշարժան։
«Իմ մորաքույրը շուտով կգա, պարոն Նաթել», — ասաց շատ ինքնատիրապետված տասնհինգամյա երիտասարդ աղջիկ. — «մինչ այդ դուք պետք է փորձեք և համակերպվեք ինձ հետ»։
Ֆրամտոն Նաթելը ուզում էր ասել ճիշտը, որը պետք է լավ կերպով գովաբաներ այդ պահին գտնվող զարմուհուն՝ առանց չափազանցորեն անտեսելու այն մորաքրոջը, ով պետք է գար։ Անձնականում նա ավելի քան երբևէ երկմտում էր, թե արդյոք մի շարք լրիվ անծանոթների այս պաշտոնական այցելությունները շատ բան կանեին օգնելու նյարդային բուժմանը, որը նա պետք է անցներ։
«Ես գիտեմ, թե ինչպես է դա լինելու», — ասել էր նրա քույրը, երբ նա պատրաստվում էր գաղթել այս գյուղական հանգստավայրը, — «դու քեզ կթաղես այնտեղ և չես խոսի ոչ մի կենդանի հոգու հետ, և քո նյարդերը ավելի վատ կլինեն, քան երբևէ՝ տխրությունից։ Ես քեզ պետք է ուղղակի տամ ծանոթացման նամակներ այնտեղի բոլոր ինձ ծանոթ մարդկանց։ Նրանցից մի քանիսը, ինչքան ես հիշում եմ, բավականին բարի էին»։
Ֆրամտոնը մտածում էր, թե արդյոք տիկին Սափլթոնը՝ այն տիկինը, ում նա ներկայացնում էր ծանոթացման նամակներից մեկը, մտնում էր այդ բարի բաժնի մեջ։
«Դու այստեղից շատ մարդկանց ճանաչո՞ւմ ես», — հարցրեց զարմուհին, երբ նա եզրակացրեց, որ նրանք բավական լուռ հաղորդություն են ունեցել։
«Հազիվ մի ոգի», — ասաց Ֆրամտոնը։ «Իմ քույրը մնում էր այստեղ, գիտեք, մոտ չորս տարի առաջ, և նա ինձ տվեց ծանոթացման նամակները այստեղի մարդկանցից մի քանիսի»։
Նա վերջին հայտարարությունն արեց հստակ ափսոսանքի տոնով։
«Ուրեմն դուք գործնականում ոչինչ չգիտե՞ք իմ մորաքրոջ մասին», — շարունակեց ինքնավստահ երիտասարդ աղջիկը։
«Միայն նրա անունն ու հասցեն», — խոստովանեց զանգահարողը։ Նա հետաքրքրվում էր՝ տիկին Սեփլթոնը ամուսնացած է, թե այրիացած։ Սենյակի մասին անորոշ ինչ-որ բան, կարծես, տղամարդկանց բնակության մասին էր խոսում։
«Նրա մեծ ողբերգությունը տեղի ունեցավ ընդամենը երեք տարի առաջ», — ասաց երեխան, — «դա կլիներ քո քրոջ ժամանակներից»։
«Նրա ողբերգությո՞ւնը», — հարցրեց Ֆրամտոնը, — այս հանգիստ գյուղական վայրում ողբերգությունները ինչ-որ կերպ անտեղի էին թվում։
«Դուք կարող եք զարմանալ, թե ինչու ենք մենք այդ պատուհանը լայն բաց պահում հոկտեմբերյան կեսօրին», — ասաց զարմուհին՝ ցույց տալով մեծ ֆրանսիական պատուհանը, որը բացվում էր դեպի մարգագետին։
«Տարվա եղանակի համար բավականին տաք է», — ասաց Ֆրամտոնը, — «բայց այդ պատուհանը որևէ կապ ունի՞ ողբերգության հետ»։
«Երեք տարի առաջ այդ պատուհանից դուրս նրա ամուսինը և երկու երիտասարդ եղբայրները գնացին իրենց օրվա կրակոցների։ Նրանք այլևս չվերադարձան։ Ճահճուտով անցնելիս դեպի իրենց սիրելի դիպուկահարների կրակոցների վայրը, նրանք երեքն էլ ընկղմվեցին վտանգավոր ճահճի մեջ։ Գիտեք, այդ սարսափելի խոնավ ամառը եղել էր, և այն վայրերը, որոնք անվտանգ էին մյուս տարիներին, հանկարծակի, առանց նախազգուշացման, փլուզվեցին։ Նրանց մարմինները երբեք չգտնվեցին։ Սա էր դրա սարսափելի մասը»։ Այստեղ երեխայի ձայնը կորցրեց իր ինքնատիրապետումը և դարձավ տատանվող մարդկային։ «Խեղճ մորաքույրը միշտ մտածում է, որ մի օր նրանք կվերադառնան՝ իրենք և իրենց հետ կորած փոքրիկ շագանակագույն սպանիելը, և կմտնեն այդ պատուհանից, ինչպես նախկինում։ Ահա թե ինչու պատուհանը բաց է պահվում ամեն երեկո, մինչև լիովին մթնշաղը։ Խեղճ սիրելի մորաքույրը հաճախ է պատմել ինձ, թե ինչպես են նրանք դուրս եկել՝ իր ամուսինը՝ սպիտակ անջրանցիկ վերարկուն թևին, և Ռոնին՝ իր կրտսեր եղբայրը, երգելով «Բերտի, ինչո՞ւ ես վազում» երգը, ինչպես նա միշտ անում էր՝ նրան ծաղրելու համար, որովհետև նա ասում էր, որ դա նյարդայնացնում է իրեն։ Գիտե՞ք, երբեմն այսպիսի հանգիստ երեկոներին ես գրեթե սարսափելի զգացողություն եմ ունենում, որ նրանք բոլորը կմտնեն այդ պատուհանից»:
Նա մի փոքր դողալով ընդհատեց խոսքը։ Ֆրամտոնի համար թեթևացում էր, երբ մորաքույրը սենյակ մտավ՝ ուշանալու համար ներողություններ խնդրելով։
«Հուսով եմ՝ Վերան զվարճացրել է ձեզ», — ասաց նա։
«Նա շատ հետաքրքիր է եղել», — ասաց Ֆրամտոնը։
«Հուսով եմ՝ բաց պատուհանը ձեզ չի անհանգստացնում», — աշխույժ ասաց տիկին Սեփլտոնը, — «ամուսինս և եղբայրներս անմիջապես տուն կգան որսից, և նրանք միշտ այս կերպ են գալիս։ Նրանք այսօր ճահճուտներում մոծակ որսալու էին գնացել, այնպես որ, լավ խառնաշփոթ կստեղծեն իմ խեղճ գորգերի վրա։ Այնպես որ, ինչպես դուք, տղամարդիկ, այնպես չէ՞»։
Նա ուրախությամբ շարունակեց խոսել որսորդության, թռչունների սակավության և ձմռանը բադերի հեռանկարների մասին։ Ֆրամտոնի համար այդ ամենը պարզապես սարսափելի էր։ Նա հուսահատ, բայց միայն մասամբ հաջողված ջանք գործադրեց զրույցը տեղափոխելու ավելի քիչ սարսափելի թեմայի վրա, նա գիտակցում էր, որ իր տանտիրուհին իրեն ուշադրությունից միայն մի փոքր մասն էր նվիրում, և նրա աչքերը անընդհատ շեղվում էին նրա կողքով՝ դեպի բաց պատուհանը և դրա հետևում գտնվող մարգագետինը։ Անշուշտ, դժբախտ պատահաբար էր, որ նա պետք է այցելեր այս ողբերգական տարելիցին։
«Բժիշկները համաձայն են ինձ լիակատար հանգիստ, մտավոր գրգռվածության բացակայություն և բռնի ֆիզիկական վարժություններից խուսափելու հարցում», — հայտարարեց Ֆրամտոնը, որը տառապում էր այն տանելիորեն տարածված մոլորությամբ, որ բացարձակ անծանոթներն ու պատահական ծանոթները ծարավ են մարդու հիվանդությունների և թուլությունների, դրանց պատճառի և բուժման ամենափոքր մանրամասնության նկատմամբ։ «Սննդակարգի հարցում նրանք այդքան էլ համաձայն չեն», — շարունակեց նա։
«Ո՛չ», — ասաց տիկին Սեփլտոնը ձայնով, որը վերջին պահին փոխարինեց հորանջին։ Ապա նա հանկարծ պայծառացավ՝ ուշադրությունը սևեռելով, բայց ոչ թե Ֆրամտոնի ասածներին։
«Ահա և նրանք վերջապես», — բացականչեց նա։ «Հենց թեյի ժամանակին, և մի՞թե նրանք աչքերից մինչև ցեխոտ չեն թվում»։
Ֆրամտոնը թեթևակի դողաց և շրջվեց դեպի զարմուհին՝ հայացքով, որը նպատակ ուներ արտահայտել համակրանքի զգացում։ Երեխան նայում էր բաց պատուհանից՝ աչքերում ապշած սարսափով։ Անանուն վախի սառը ցնցումով Ֆրամտոնը շրջվեց իր նստատեղին և նայեց նույն ուղղությամբ։
Խորացող մթնշաղին երեք կերպարանք քայլում էին մարգագետնի վրայով դեպի պատուհանը, բոլորը զենքեր էին կրում թևատակերի տակ, և նրանցից մեկը լրացուցիչ ծանրաբեռնված էր սպիտակ վերարկուով, որը կախված էր ուսերին։ Հոգնած շագանակագույն սպանիելը հետևում էր նրանց։ Նրանք անձայն մոտեցան տանը, և հետո մի խռպոտ երիտասարդ ձայն մթնշաղից երգեց. «Ես ասացի, Բերտի, ինչո՞ւ ես վազում»։
Ֆրամտոնը վայրենաբար բռնեց իր ձեռնափայտն ու գլխարկը։ Դահլիճի դուռը, խճաքարե ճանապարհը և առջևի դարպասը նրա գլխապտույտ նահանջի մշուշոտ փուլերն էին։ Ճանապարհով ընթացող հեծանվորդը ստիպված էր բախվել ցանկապատին՝ անխուսափելի բախումից խուսափելու համար։
«Ահա մենք, սիրելիս», — ասաց սպիտակ մակինտոշ կրողը, մտնելով պատուհանից, — «բավականին ցեխոտ է, բայց մեծ մասը չոր է։ Ո՞վ էր այն, որ փախավ, երբ մենք մոտեցանք»։
«Շատ արտասովոր մարդ, պարոն Նատել», — ասաց տիկին Սապլտոնը, — «կարող էր միայն խոսել իր հիվանդությունների մասին և շտապեց առանց հրաժեշտի կամ ներողության խոսքի, երբ դուք ժամանեցիք։ Կարելի էր մտածել, որ նա ուրվական է տեսել»։
«Կարծում եմ՝ սպանիելն էր», — հանգիստ ասաց զարմուհին։ «Նա ինձ ասաց, որ սարսափում է շներից։ Մի անգամ նրան Գանգեսի ափին գտնվող գերեզմանոցում որսացին մի խումբ պարիա շներ, և նա ստիպված եղավ գիշերել նոր փորված գերեզմանում, որտեղ արարածները մռնչում, ժպտում և փրփրում էին նրա գլխավերևում։ Բավական է, որ ցանկացած մեկը կորցնի իր համարձակությունը»։
Արագ ծավալվող սիրավեպերը նրա մասնագիտությունն էին։
Մեր ճամբարի ընթացքում կատարեցինք կենսաբանական փորձ, որտեղ ուսումնասիրեցինք տարբեր բաներ մանրադիտակի տակ, թե ինչ են դրանք և ինչպես են աշխատում:
Ամենակարևորը ուսումնասիրեցինք արյան ձևավոր տարրերը՝ էրիթրոցիտը, թրոմբոցիտը և լեյկոցիտը: Դրանք ապակու վրա էին և ներկված հատուկ ներկով, որպեսզի բոլոր տարրերը երևան: Մեծ մանուշակագույն տարրերը լեյկոցիտներն են, միջինները՝ էրիթրոցիտները, իսկ մանր հատիկները՝ թրոմբոցիտները: Դրանք ունեին այսպիսի տեսք.

Էրիթրոցիտները հեմոգլոբինի միջոցով թոքերից թթվածին են մատակարարում մարմնի բոլոր բջիջներին և հետադարձաբար ածխաթթու գազը հեռացնում դեպի թոքեր՝ ապահովելով գազափոխանակությունը։ Լեյկոցիտները օրգանիզմի իմունային պաշտպանության համար են՝ պայքարելով վարակների, օտարածին մարմինների, բակտերիաների և վիրուսների դեմ։ Իսկ թրոմբոցիտները արյան մակարդման համար են։ Վնասվածքի դեպքում դրանք հավաքվում են վնասված տեղում՝ առաջացնելով խցան, որը կանխում է արյունահոսությունը և նպաստում վերքի բուժմանը։
Նաև ուսումնասիրեցինք տերևի հյուսվածքը, նայել ենք հերձանցքները, որոնք սուրճի հատիտի նման բջիջներ են, որոնք բացվելով և փակվելով կարգավորում են ջրի գոլորշիացման պրոցեսը՝ պաշտպանելով բույսը չորացումից և գերխոնավությունից։

Մոտավորապես 1000 տեսակի սնկային տեսակներ՝ Microsporidia, Chytridiomycota, Entomophthoromycota (կարգի՝ Entomophthorales), Basidiomycota և Ascomycota, հայտնի են միջատներին վարակելու և սպանելու ունակություններով։
Ինչպես են գործում այս սնկերը

Որոշ սնկային տեսակներ, մասնավորապես Ophiocordyceps unilateralis, ունեն յուրահատուկ մեխանիզմներ, որոնց միջոցով նրանք վարակում են միջատներին՝ օգտագործելով նրանց մարմինները որպես աճման միջավայր։ Այս սնկերը հայտնի են իրենց ունակությամբ՝ միջատներին դարձնելու «զոմբիներ»՝ վերահսկելով նրանց վարքագիծը՝ հանուն սնկի վերարտադրության։
Վարակումից հետո սունկը սկսում է աճել միջատի մարմնի ներսում՝ աստիճանաբար տարածվելով նրա հյուսվածքներով։ Միևնույն ժամանակ, այն արտադրում է քիմիական միացություններ, որոնք ազդում են միջատի կենտրոնական նյարդային համակարգի վրա։ Արդյունքում միջատը սկսում է անսովոր վարք դրսևորել՝ բարձրանում է բույսի վրա, ընտրում է ստվերոտ, խոնավ վայր ու ուժեղ բռնում է տերևին կամ ցողունին։
Այսպես կոչված «մահվան կծումից» հետո միջատը մահանում է, իսկ սունկը դուրս է գալիս նրա մարմնից՝ հաճախ գլխի հետևի մասից, ձևավորելով երկարաձիգ կառուցվածք, որն արտադրում է նոր սպորներ։ Այս սպորները տարածվում են օդով և վարակում նոր միջատների՝ շարունակելով ցիկլը։
Ինչպես է սունկը վարակում միջատին
Որոշ սնկեր վարակում են միջատներին շփման միջոցով՝ իրենց սպորները կպցնելով միջատի մարմնին։ Այս սպորները կա՛մ կրում են գործիքներ՝ միջատի կոշտ արտաքին թաղանթը (կուտիկուլը) ծակելու համար, կա՛մ արտազատում են ֆերմենտներ՝ այն քայքայելու համար։ Կուտիկուլը կազմված է խիտին-սպիտակուցային խառնուրդից՝ մոմային արտաքին շերտով, որը կազմում է միջատի էկզոսկելետը։

Մտնելով ներս, սունկը փոխում է ձևը՝ արագ աճելով և խուսափելով միջատի իմունային համակարգից։ Այն տարածվում է միջատի մարմնով՝ վնաս պատճառելով, երբեմն՝ տոքսինների օգնությամբ։ Ի վերջո, միջատը մահանում է։ Դրանից հետո սունկը կարող է կամ աճել մարմնի վրա և արտազատել ավելի շատ սպորներ՝ ուրիշներին վարակելու համար, կամ կարող է ձևավորել ավելի մեծ կառուցվածք (ինչպես սունկ), որը ստեղծում է սեռական սպորներ։
Որոշ սնկեր կարող են նաև գոյատևել հողում՝ բույսերի արմատների հետ կապ ստեղծելով։ Նրանք միջատի մարմնից բույսին տալիս են ազոտ և փոխարենը ստանում ածխածին։ Սա օգնում է սնկին կենդանի մնալ նույնիսկ այն դեպքում, երբ վարակելու համար միջատներ չկան։
Ինչ է կատարվում միջատի վարքի հետ
Կորդիցեպս (լատ. Ophiocordyceps unilateralis) — սնկի տեսակ է, որն պարազիտ է ծառերի մրջյունների (Camponotus leonardi) վրա։ Այն հայտնաբերվել է 1859 թվականին բրիտանացի բնագետ Ալֆրեդ Ուոլեսի կողմից։ Տարածված է արևադարձային անտառներում։ Այս սնկի առանձնահատկությունն այն է, որ այն փոխում է օրգանիզմի վարքը՝ դրսևորելով պարազիտի ադապտիվ մանիպուլյացիա։

Պարազիտով վարակվելուց մոտ 2-3 շաբաթ անց վարակված մրջյունը լքում է մրջնաբույնը, բարձրանում բույսի վրա և ամրանում է տերևի վրա՝ սրանով սունկը ապահովում է իր սպորների տարածման լավագույն դիրքը։ Սա «զոմբիացման» փուլն է․ սունկը ղեկավարում է միջատի քայլերը իր կարիքների համար։
Սնկի այս վարքագիծը համարվում է «ընդլայնված ֆենոտիպ»՝ երբ օրգանիզմը փոխում է իր հյուրընկալի վարքը՝ իր սեփական վերարտադրությունը ապահովելու համար։ Այս տեսակին պատկանող պարազիտիկ սնկերը նույնիսկ 48 միլիոն տարի առաջ էին վերահսկում մրջյունների վարքը, ինչի մասին վկայում է Գերմանիայի Մեսելի կարիերից գտնված քարացած նմուշը։
Աշխատանքը կատարել են՝ Նանե Խաչատրյան, Իրինա Գյուրջինյան, Գոհար Բարսեղյան
Գիտաֆանտաստիկ ժանրը մեծ վերելք ունեցավ 20-րդ դարում: Դրա գրողները կային ամբողջ աշխարհով մեկ: Խորհրդային Միության մեջ նույնպես, օրինակ՝ Ստրոգացկի եղբայրները, Իվան Եֆրեմով, Ալեքսանդր Բելյաև և այլն: Սակայն Հայաստանում այս ժանրը այդպես էլ չզարգացավ:
Չնայած նրան, որ Խորհրդային Հայաստանում բավականին լավ էր զարգացած գիտությունը՝ ֆիզիկա, աստղաֆիզիկա, մաթեմատիկա, ռադիոֆիզիկա, որոնք մեծ դեր ունեն գիտաֆանտաստիկ ժանրի համար, սակայն դրանք չեն ազդել մեր գրականության վրա: Դրա համար կային մի քանի պատճառ:
Հայ գրողների մեծամասնությունը գրում է հայրենիքի մասին: Սա կապված է պատերազմների և ցեղասպանության հետ, քանի որ դրանք մեծ ազդեցություն են թողել հայ սերունդների վրա: Գրականությունը շատ հաճախ ծառայել է որպես ինքնության պահպանման միջոց, և դրա նպատակն ավելի շատ եղել է հիշողությունը կենդանի պահելը, քան ապագայի երևակայական աշխարհներ ստեղծելը։
Նաև, հայ իրականության մեջ ապագան հաճախ ընկալվել է անորոշ կամ վտանգավոր՝ քաղաքական խնդիրների, պատերազմների պատճառով։ Այս մթնոլորտը կարող էր խանգարել այնպիսի ժանրի զարգացումը, որի համար պետք է լավ երևակայություն և կայուն հասարակական հիմք։
Կային գիտաֆանտաստիկ սփյուռքահայ գրողներ, օրինակ՝ Քրիս Բոհջալյան, Վերա Նազարյան, Ջո Կասաբյան, Պիտեր Օրուլյան և այլն, ովքեր սակայն Հայաստանում չէին ապրել և չէին մեծացել այս միջավայրում: Նրանց ստեղծագործությունները հաճախ գրվում են անգլերենով, այդ պատճառով էլ դրանք քիչ հայտնի են հայկական հասարակության շրջանում։
Հիմա քիչ-քիչ զարգանում է գիտաֆանտաստիկ ժանրը Հայաստանում և հայտնվում են ավելի շատ գրողներ, ովքեր հետաքրքրվում են այս թեմայով: Այս ժանրը կարող է մեծ դեր ունենալ նոր սերնդի երևակայությունն ու ստեղծագործական միտքը զարգացնելու գործում։
Մալայզիան շատ տարբեր մշակույթներ ունի, և յուրաքանչյուր խումբ ունի իր հատուկ տոները: Օրինակ, մուսուլմանները նշում են Հարի Ռայա Պուասան Ռամադան ամսվա վերջում, իսկ Հարի Ռայա Հաջին՝ Մեքքա ուխտագնացությունից հետո: Բուդդայականները նշում են Բուդդայի կյանքը Հարի Վեսակի վրա, չինացի մալայզիացիները նշում են չինական Նոր տարին, իսկ հնդիկ մալայզիացիները վայելում են Deepavali (լույսերի փառատոնը): Քրիստոնյաները նշում են Սուրբ Ծնունդը.
Այս տոների ժամանակ մարդիկ հաճախ ունենում են «բաց դռներ», որտեղ ցանկացած մարդ կարող է մտնել, համեղ ուտելիքներ և իրեն ընդունելի զգալ։ Օգոստոսի 31-ին բոլորի համար կա նաև մեծ ազգային տոն, որը կոչվում է Հարի Քեբանգսաան, որը նշում է Մալայզիայի անկախությունը:
Որոշ նահանգներ նույնպես ունեն իրենց արձակուրդները: Օրինակ, Սարավակը նշում է Գավայ Դյակը, որը հարգում է տեղական բնիկ խմբերի ավանդույթները, ինչպիսիք են Իբանը և Բիդայուն:
Բացի այս տոներից, մարդիկ նշում են նաև կյանքի մեծ իրադարձություններ, ինչպիսիք են ծնունդները, հարսանիքները կամ նույնիսկ թլպատումը (երիտասարդ մահմեդական տղաների համար): Սրանք մալայերեն կոչվում են kenduri և ներառում են մեծ կերակուր: Հարսանիքները հատկապես կարևոր են և կարող են լինել մեծ տոնակատարություններ՝ կա՛մ տանը՝ գյուղերում, կա՛մ հյուրանոցներում և քաղաքների սրահներում:
Մալայզիայի մշակույթը բազմազան է և միախառնված է ազդեցությունների ինչպես արևելքից, այնպես էլ արևմուտքից: Տարբեր էթնիկ խմբերով ընդգրկված էկլեկտիկ բնակչությամբ Մալայզիան հանդիսանում է ավանդույթների և սովորույթների փառահեղ հալման կաթսա, որը ընդգրկում է սերունդներ: Սա, զուգորդված արևմտյան զգայունության հետ, ներկայացնում է յուրահատուկ համադրում, որը հաճելի է փորձի համար:
Մալայզիայի գրականությունը ներկայացնում է մալայզիական կյանքի տարբեր ասպեկտներ և կազմում է Մալայզիայի մշակույթի կարևոր մասը: Մալայզիայի գրականության ամենավաղ ստեղծագործությունները փոխանցվել են բանավոր՝ սցենարների բացակայության դեպքում:Բանավոր գրականությունը ներառում է մալայական բանահյուսության մի շարք ժանրեր, օրինակ՝ առասպելներ, լեգենդներ, ժողովրդական հեքիաթներ, սիրավեպեր, էպոսներ, պոեզիա, ասացվածքներ, ծագման պատմություններ և բանավոր պատմություններ։ Բանավոր ավանդույթը բարգավաճեց մալայացիների շրջանում, բայց շարունակում է գոյատևել Մալայզիայի բնիկ մարդկանց, այդ թվում՝ Օրանգ Ասլիի և բազմաթիվ էթնիկ խմբերի մոտ Սարավակում և Սաբահում:
Վաղ մալայական գրականությունը կրել է հնդկական էպոսների ազդեցությունը, ինչպիսիք են Մահաբհարաթան և Ռամայանան, որոնք հետագայում ներառում են այլ ավանդույթներ, որոնք այժմ կազմում են մալայական գրական ժառանգությունը: Գոյություն ունեին նաև մալայական պոեզիայի մի քանի ձևեր, որոնք մինչ օրս տարածված են մնում։
19-րդ դարում Մալայական թերակղզում բանավոր գրականությունը փոխարինվեց գրավոր գրականությամբ։ Սա մասամբ վերագրվում էր 15-րդ դարում թերակղզի իսլամի ներմուծմանը և ջավիի գրի ընդունմանը: Այս ավանդույթի վրա ազդել են ինչպես ավելի վաղ բանավոր ավանդույթները, այնպես էլ Մերձավոր Արևելքի իսլամական գրականությունը: Այս ընթացքում ստեղծագործությունները տատանվում էին աստվածաբանական գրականությունից և իրավական բովանդակությունից մինչև ռոմանսներ, բարոյական անեկդոտներ, իսլամական մարգարեների հայտնի հեքիաթներ և նույնիսկ կենդանիների հեքիաթներ, որոնք գրված էին մի շարք ոճերով:
Շատերը գիտեն Եղիշե Չարենցին որպես սիրային և հայրենասիրական թեմաներով գրող, սակայն նա նաև եղել է քաղաքական մտածող: Իր որոշ ստեղծագործություններում նա ցույց էր տալիս Խորհրդային միության վատ կողմերը և սոցիալական ու քաղաքական իրադարձությունները՝ հեղափոխություններ, բռնապետություններ և տարբեր ռեժիմներ։
Խորհրդային միության սկզբում իր ստեղծագործություններում կարելի է տեսնել Չարենցի ոգևորությունը՝ փոփոխությունների պատճառով: Նա կարծում էր, որ այս փոփոխությունները կբերեին ազատություն, արդարություն և համերաշխություն: Այդպիսի ստեղծագործություններից էին՝ «Ամբոխները խելագարված», «Հասել է ժամ»: Սակայն մի քանի տարի անց կարելի է նկատել իր ստեղծագործությունների մեջ փոփոխություն՝ կային ակնարկներ Խորհրդային միության սահմանափակումների մասին, սակայն նա չէր կարող դրանց մասին ակնհայտ գրել՝ նա համարվում էր խորհրդային պոետ, և գիտեր, որ հալածանքի կարժանանար: Չարենցը գնալով ավելի և ավելի էր հիասթափվում խորհրդային կարգից, տեսնում էր բռնություն և հալածանք, իր ստեղծագործությունները է՛լ ավելի քաղաքական և քննադատող են դառնում:
Այս աստիճանական փոփոխությունը տեսնելու համար պետք է կարդալ Եղիշե Չարենցի ստեղծագործություններից՝ «Ամբոխները խելագարված», «Մարիանետկա», «Սովետական աշխարհ», «Տաղարան», «Թիֆլիսի կինտոն», «Իմ մահվան օրը կիջնի լռություն», «Գիրք ճանապարհի» և այլն:
1935թ. նա դուրս եկավ Գրողների միությունից՝ խնդրելով դա չկապել քաղաքականության հետ, սակայն նրան տնային կալանքի տակ դրեցին, իսկ 1937թ. նրա դեմ կատարվում էին քաղաքական հալածանքներ, իր բնակարան ներխուժեցին և տարան բանտ՝ մեղադրելով ազգայնականության, հակահեղափոխականության և ահաբեկչության մեջ: Նոյեմբերի 27-ին նա մահանում է բանտի հիվանդանոցում, սակայն դեռ հստակ պարզ չէ, թե ինչպես, և կան մի քանի վարկածներ:
Եթե սպանություն էր կատարվել Խորհրդային ղեկավարների կողմից, ապա պարզ է, որ նրանք վախենում էին, որ իրենց ճնշված ժողովուրդը կարող է ապստամբել և փորձել ազատվել բռնությունից ու անարդարությունից, հատկապես երբ հակախորհրդային տեսակետներ էր արտահայտում հայտնի և հարգված մարդ: